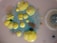
Various colonies of bacteria and fungi, including bright yellow and blue growths, are visible on an agar dish. The colonies appear in different sizes and textures, highlighting diverse morphological characteristics. There's a cluster of dense yellow formations amidst scattered blue specks, and a grayish, fuzzy circle to the right.

Mikrobiyota ve Probiyotik Araştırmaları
Mikrobiyota ve probiyotik nakli alanında ulusal ve uluslararası araştırmaları desteklemek amacıyla kurulmuş bir derneğiz.


10+
100+
Bilimsel Yayınlar
Uluslararası Kongreler
Mikrobiyota Araştırmaları
Mikrobiyota ve probiyotik nakli üzerine araştırmalar desteklenmektedir.


Kongre ve Sempozyum
Ulusal ve uluslararası toplantılar düzenlenmektedir sağlık için.


Bilimsel Yayınlar
Gastrointestinal sistem ve karaciğer hastalıkları üzerine yayınlar.




Araştırma Destekleri
Mikrobiyota ile ilgili araştırmalara destek sağlanmaktadır.
Eğitim ve Bilgilendirme
Mikrobiyota ve prebiyotikler hakkında eğitimler düzenlenmektedir.
→
→
→
→

MIPNAD, mikrobiyota ve probiyotik nakli konusunda önemli araştırmalara destek veriyor. Teşekkürler!
Tolga B.
Mikrobiyota araştırmaları alanında yapılan çalışmalar, sağlık için büyük bir umut kaynağı. Harika bir dernek!
Ekin K.

